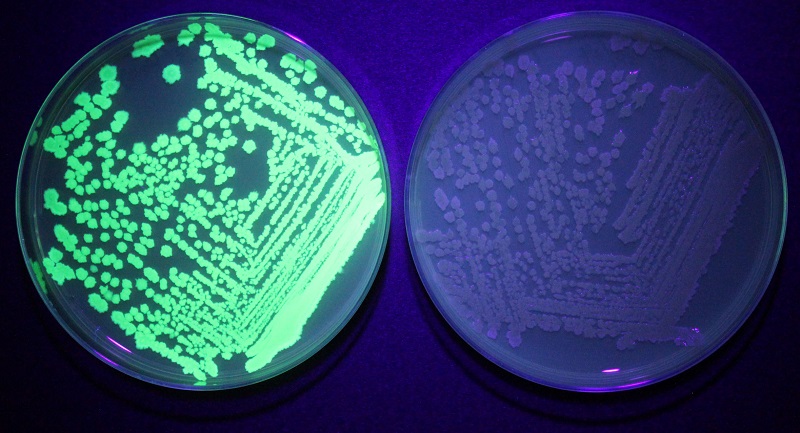

【生物科学科】生物って面白い!
生物って面白い!っと私は思っているのですが、他の先生はどういう思いなんだろう?そんな不思議に答えるためのブログを作ってみました。生物を科学する本学科には、10名の専任教員がおり、生物を形作る有機物から、細胞、バクテリア、酵母(真核生物単細胞)、植物、動物を対象に様々な視点で研究をしています。生物は、「膜を持ち、複製し(子孫を作り)、代謝する」特徴を共通して持っていますが、その多様性には驚くばかりです。学科では、生物の個体としての機能を研究する教員と、生態系における生物の役割や由来を研究する教員がおります。生物科学科の佐藤が学科の教員に生物を学ぶ面白さを聞いてみました。
有機物の何が面白い?
【岩本教授に聞いてみました】ブヨブヨ、プルプルした物質の研究:コンニャクやゼリー、寒天のように柔らかくてブヨブヨ、プルプルした物質はゲルと呼ばれ、その中で水を多く含む物をヒドロゲルと言います。ヒドロゲルは柔らかく、押すと簡単にへこみますが、放すとすぐに元に戻ります。その正体は、水に不溶な高分子物質のネットワーク構造が大量の水を抱えて膨潤したもので、ある時は固体、ある時は液体として振る舞います。人が作る構造物はコンクリートや金属のような硬い物(ハードマター)で作られていますが、私たち生物の体は多くの水を含み、骨や歯、殻など硬い物を除くと、ほとんどがゲルでできています。つまり生命現象の多くは、ソフトでウェットなゲルを舞台に行われているのです。柔軟に自己組織化して秩序構造や階層構造を作ることができるヒドロゲルの能力は、ある意味生物の体が持つ機能の根幹をなすもので、ゲルの理解は生物の体の理解につながります。私たちの研究室では、バイオマスのような天然物から様々な機能を持つヒドロゲル(バイオベースポリマー)を作り、医用材料などに応用できないか研究しています。

写真提供:西村 真樹 氏
バクテリアの何が面白い?
【広岡教授に聞いてみました】枯草菌は、納豆などの発酵食品の製造に利用される身近な微生物ですが、グラム陽性細菌のモデルとして遺伝子や代謝についての研究が広範かつ詳細になされています。とはいえ、枯草菌がもつすべての遺伝子の働きや細胞内外のすべての代謝が明らかになっているわけではなく、未知のものを1つずつさまざまな手法を使って解明することはゲーム攻略に似た面白さがあります。また、機能が明らかになった遺伝子の仕組みを利用して物質生産に応用する研究も行っていますが、これにはDNAというさまざまなパーツを組み合わせて自分好みの枯草菌に仕立てる、PCやロボットを自作するのに通じる面白さがあります。もちろん枯草菌1細胞は肉眼では見えないほど小さいですが「生き物」ですので、必ずしも我々人間が思った通りになってくれるとは限りません。しかし、思い通りに改良できたときの喜びはひとしおです。枯草菌は人畜無害ですがこの菌で得られた知見をもとに病原菌についての研究が行われており、新たな防除法や感染症治療法の開発につながるものと期待されます。このように、枯草菌研究は多くの可能性を秘めており、未知の領域を探索する楽しさと、実際に役立つ発見をする喜びがたくさんあります。
酵母の何が面白い?
【久冨教授に聞いてみました】酵母研究の面白さは、基礎研究から実用研究までを幅広くカバーするところにあります。酵母菌(イースト)は私達に最も身近な微生物で、1万年近く前からパンやビール、ワインなどを製造するのに使われてきました。我々人間と同じ真核生物ですが、単細胞で生活しており、容易に増殖させることができて、突然変異体などの分離や解析も可能です。私達の研究室では、酵母の種多様性の機構をライフサイクルの観点から遺伝子レベルで解析しています。また、地域に生息する野生の酵母を発掘して、地場産業の活性化につながるような実用研究を進めています(福山バラの酵母プロジェクト)。基礎と応用をシャトルするようなダイナミックな研究が魅力です。

【松崎教授に聞いてみました】酵母はパンや日本酒の製造に使用されていますが、寿命や癌発生など生命の仕組みの解明や健康問題、エネルギー問題、環境問題など社会問題の解決にも利用されています。私たちは、染色体が子孫細胞に安定に伝達される仕組みを明らかにして健康に役立てたいと考えています。また、その仕組みを利用して染色体を改変して品種改良を行う技術も開発できます。さらに、遺伝子組換え技術で廃棄物である古紙や廃材などを分解してバイオ燃料を生産できる酵母の開発を行っています。植物由来の燃料ということで、カーボンニュートラルによる脱炭素社会の構築に貢献できます。このように、酵母は色んな可能性を秘めていて面白いです。

ワインの何が面白い?
【吉﨑准教授に聞いてみました】生物科学の観点からワインを学ぶことには多くの意義があります。まず、発酵プロセスに関わる酵母や乳酸菌などの研究を通じて微生物学の知識が深まります。ブドウ栽培に関しては、植物生理学や遺伝学の理解が進み、科学的な栽培方法の理解に繋がります。また、ワインの化学成分の解析には、様々な化学物質の分離・同定の知識が必要です。さらに、持続可能な農業実践や気候変動の影響を考慮した環境科学の視点も不可欠です。バラバラだった知識が“ワイン”を核に有機的に繋がり、生物学の基礎から応用、人類が直面している地球規模の問題まで理解を深めることができます。

植物の何が面白い?
【原口特任教授に聞いてみました】昨年末、アラブ首長国連邦のドバイでCOP28が開催され(今年はアゼルバイジャンでCOP29があります)、地球温暖化の大きな原因である温室効果ガス(CO2、CH4、N2Oなど)の排出改善の検証や今後の削減目標ついて検討がなされました。現在のような社会生活・産業活動をこれまでのシステムで続ける(多量の電力を使い、鉄を作り、大規模輸送を行う)ならば、二酸化炭素の排出がゼロになることはあり得ません。そこで、カーボン・ニュートラルという概念が必要になります。ヒトの社会活動では多量のCO2が排出されていますが、地球上でCO2を吸収しているシステムは植物による光合成です。高等植物の光合成では、CO2から有機物(糖)を合成します。この有機物が地球上の80億の人々の食料になっています。日本などではお腹いっぱいご飯が食べられていますが、そうでない地域が圧倒的に広く、地球レベルでは食糧不足です。植物の光合成の機能をさらに解明し、その能力を発揮させることにより、時間はかかるかもしれませんが、グローバルな諸問題を解決できるでしょう。

動物の何が面白い?
【自分自身に聞いてみました】DNAという物質の中には太古の歴史の記録が詰まっています。それらを紐解くことで、動物の進化を明らかにすることは、とてもワクワクする試みです。進化というのは、1個体だけを見ていても何もわかりません。個体が集まった集団単位でその特徴を分析し、そして世代を超えて見られる小さな変化を探るものです。なかなか大変な研究ですが、進化の痕跡を見つけた時の喜びは大きなものです。最近『進化生物学』という学部生向けの本を書きました。進化に興味のある皆さん、ぜひ、読んでみてください。動物が残した糞などの痕跡から生態系を理解することもできます。人知れず私たちの周りで活動する小さなネズミたちの生態系における大きな役割が見えてきました。まだまだ謎の多い動物の進化と生態を明らかにしてみませんか?

【石塚講師に聞いてみました】動物の行動の意味を解き明かすことが面白いと感じています。野外の動物は実に多様な行動を見せてくれます。その行動の一つ一つには、自然界を生き抜くためのヒントが隠されています。そんな動物の行動を紐解くため、彼らの生息地でフィールドワークを行う研究をしています。フィールドワークには困難が伴うこともありますが、現場で動物と向き合い、もの言わぬ彼らの謎を紐解いた時の喜びはひとしおです。ぜひ動物の謎を解き明かすフィールドワークに出かけましょう。

以上、生物を学ぼうとしている皆さん、生物学ってこんなに面白い学問なのです。環境、資源、健康をよりよく理解するためには生物の理解が必要です。現代社会に必要なのは「生物をよく理解した人」に違いありません。ここは私を信じて、生物科学科で生物を学んでみませんか?まずは、6月22日(土)のオープンキャンパスでお会いしましょう。
学長から一言:生物科学科所属の教員の皆さんは、人それぞれ「面白い」と感じる対象が違っていても、ほぼ共通なのは大きなモノから小さなモノまで、いずれも「生き物」(植物も生きていますから)だということ。いわば、福大の「いきものがかり」。そして、日々ひたすらその面白さを追究している人たちだということが分かります。各人の言葉の中に研究への飽くなき情熱を垣間見ました。




